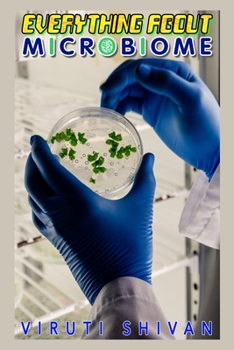
Paperback Everything About Microbiomes: Understanding Your Microbiome and Its Impact on Your Health Book

Everything About Microbiomes: Understanding Your Microbiome and Its Impact on Your Health
Discover the fascinating world of microbiomes with our comprehensive guide. This book aims to unravel the intricacies of the microscopic organisms living within us and their significant role in our health and well-being. Through this book, learn about the diversity of microbiota, their critical roles in our body's functions, and the influence of diet and lifestyle on our microbiomes. Uncover how a healthy microbiome can boost your immunity, improve your digestion, and even enhance your mood. From the latest research to practical tips on fostering a healthy microbiome, this book is your essential guide to understanding this unseen universe within us. If you are interested in health, nutrition, and cutting-edge science, then exploring the world of microbiomes will take you on an exciting and insightful journey towards a healthier life.
Format:Paperback
Language:English
ISBN:B0CCZWRZLS
ISBN13:9798854223430
Release Date:July 2023
Publisher:Independently Published
Length:74 Pages
Weight:0.24 lbs.
Dimensions:0.1" x 6.0" x 9.0"
Customer Reviews
0 rating